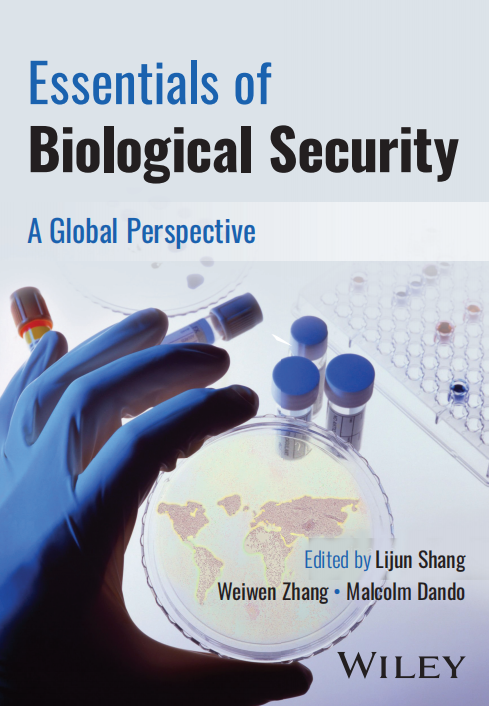

本站讯(通讯员 宋洁)12月13日上午,天津大学与英国伦敦城市大学在日内瓦万国宫共同主办“从《科学家生物安全行为准则天津指南》到‘国际生物安全教育网络(IBSEN)’”联合国边会,推介由主办方牵头完成的首本国际生物安全教材——《Essentials of Biological Security》,凝聚国际科学家力量,发展基于《科学家生物安全天津指南》(以下简称《天津指南》)的生物安全国际教育网络。
会议吸引了包括美国、欧盟、英国、俄罗斯、意大利、新加坡、古巴、韩国、苏丹等国家以及国际机构共50余名代表参会。


天津大学举办《禁止生物武器公约》联合国边会
此次边会由我校生物安全战略研究中心张卫文教授主持,常务副校长胡文平致欢迎辞。致辞中胡文平分析了国内和国际生物安全的挑战、生物安全产业的发展以及全球生物安全领域人才的匮乏,指出构建全球性生物安全教育体系的紧迫性。天津大学一直是国内生物安全教育改革的先行者。自天津大学牵头完成的《天津指南》发布以来,生物安全教育从教学内容到教学方法正在不断创新,希望通过吸引更广泛的国际参与,共同构建全球生物安全教育网络。

天津大学常务副校长胡文平在联合国边会上致辞
英国伦敦城市大学副校长Don MacRaild先生致辞,Don MacRaild先生表示过去的新冠肺炎疫情让我们意识到有必要加强《禁止生物武器公约》与社会的力量,科学家的生物安全意识与生物安全教育明显不足。希望明年即将付梓出版的《Essentials of Biological Security》能够有力支持生物安全教育。
在主题演讲环节,天津大学薛杨副教授、英国伦敦城市大学Lijun Shang教授以及Maeva Khachfe女士、iGEM项目生物安全负责人包堉含先生、Biosecure公司Kathryn Millet女士(委托Lijun Shang教授)分别发言。
英国伦敦城市大学商立军教授介绍了《全球视角下的核心生物安全》这本教材的主要内容,预计该教材明年6月将由Wiley出版社出版。
(编辑 刘延俊 孟巍)